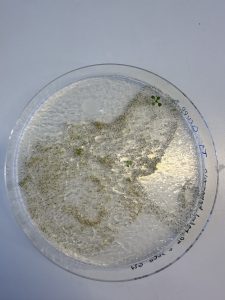

Hej alla bloggläsare!
Just nu är det den bästa årstiden i Lund enligt mig, nämligen vår! Alla träd blommar ut, solen skiner och Valborg är precis runt hörnet. Vad mer kan man önska?
I detta inlägg tänkte jag berätta om hur en vanlig vecka kan se ut för en Lundastudent, så ni ska få hänga med i min vardag! Det kommer att tas upp både plugg, fritid och träning!
Plugget
Då jag läser en kandidat i Molekylärbiologi tillhör jag den Naturvetenskapliga fakulteten. På mitt program och generellt hos mitt fakultet så har vi många föreläsningar. Dessa är inte obligatoriska men jag försöker delta på alla ändå! Det är ett lätt sätt att hänga med i studietakten och se till att man förstår allt som krävs för kursen. Ett studietips från mig är att närvara på så många moment i ens kurs som man kan.
Förutom föreläsningar har jag ibland också labbar! Dessa kan vara allt ifrån heldagar, alltså 08-17, eller ibland bara några timmar över dagen. Labbar är en del av många kurser som ges på Naturvetenskapliga fakulteten och de är ett roligt sätt att få använda teorin man lär sig i praktiken!
Jag är i skolan nästintill varje dag men ofta har man bara moment ifrån exempelvis 10-12 eller 13-15 och under sådana dagar har man mycket frihet att lägga upp plugget och ens fritid själv vilket jag uppskattar väldigt mycket!

Fritiden
Under förra veckan i Lund var det otroligt fint väder! Då jag inte hade särskilt långa dagar i skolan valde jag och mina vänner att spendera en del tid ute i Botaniska trädgården. Botaniska trädgården, även kallat Botan, är en trevlig park belägen i centrala Lund.

En av de bästa sakerna med att plugga på universitetet är att man har så mycket eget ansvar. Jag kan själv välja hur jag ska lägga upp min tid och mina dagar. Förra veckan valde jag att njuta lite extra mycket utomhus när det var soligt och pluggade istället på kvällen. Det är även väldigt populärt att sätta sig i olika parker i Lund och plugga, men personligen tycker jag det är lite svårt så jag föredrar att antingen plugga hemma eller i skolan.
Förutom mycket häng i Botan åt jag även god mat på restaurang och tog flera promenader med mina vänner!


Träning
Som student i Lund kan man gå med i olika föreningar eller klubbar som håller i olika träningspass och sporter. Det är ett roligt sätt att få lära känna nya personer! Jag är med en grupp studenter som simtränar två gånger i veckan vilket jag tycker är superkul! Det finns en grupp både för nybörjare och en för mer erfarna simmare. Simning är bara en av flera sporter som man kan utföra tillsammans med andra studenter i Lund! Det finns något för alla, oavsett om man är erfaren inom en sport eller vill prova på något nytt.
Förutom att simma så gillar jag även att springa. Det är oroligt trevligt att ta en springtur längs kullerstensgatorna i Lund, speciellt nu när vädret är så härligt!
Nu har ni fått en liten inblick i hur en vanlig vecka som Lundastudent kan se ut. Det blir allt ifrån föreläsningar och labbar till mycket häng med vänner och träning!
Ses i nästa inlägg:)
//Alice
